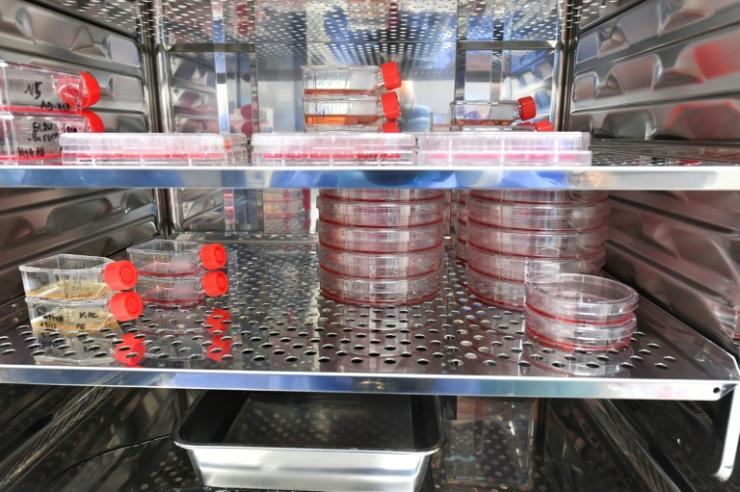
Image légendée

Cancers, immunité : les promesses de l’ARN messager dans un laboratoire d’Orléans
Publié le - par LeBlob.fr, avec l’AFP
Pour mieux combattre certains cancers, comme celui du pancréas, l’un des plus agressifs, et d’autres maladies, une équipe de chercheurs de l’Inserm, à Orléans, explore les multiples possibilités de l’ARN messager, connu du grand public depuis les vaccins développés contre le Covid-19.
Présent dans toutes les cellules, l’ARN messager leur permet de travailler au bon fonctionnement de l’organisme. Servant d’intermédiaire entre le code génétique de l’ADN et l’activité de la cellule, il permet à celle-ci de produire des protéines spécifiques. « C’est une molécule qui va copier les informations de l’ADN, pour apporter un message à la cellule immunitaire : pour le cancer, ce message sera de stimuler les capacités des malades à combattre efficacement les tumeurs », explique à l’AFP Dimitri Szymczak, chef de projet au sein de l’ART (accélérateur de recherche technologique) de l’Inserm et l’université d’Orléans, implanté dans le CHU de la ville.
En 2023, les vaccins anti-Covid à ARN messager ont valu le Nobel de médecine à la chercheuse hongroise Katalin Kariko et à l’Américain Drew Weissman, marquant l’apogée d’une révolution thérapeutique. Aujourd’hui, la course aux vaccins thérapeutiques contre le cancer est devenue mondiale, mais l’ARN recèle aussi « bien d’autres possibilités », résume Chantal Pichon, directrice de l’ART. « On peut l’exploiter pour booster l’immunité ou pallier un mauvais fonctionnement d’une cellule (…) pour les maladies métaboliques, les maladies rares, les maladies génétiques, les allergies… ». Plus de 200 essais cliniques sur l’ARN sont en cours, en majorité aux Etats-Unis, menés par les laboratoires Moderna, Pfizer, BioNTech, Merck, Sanofi… et beaucoup de jeunes entreprises américaines, mais aussi en Chine, au Japon, dit la chercheuse, qui travaille sur l’ARN depuis plus de 20 ans.

Sur ce secteur en pleine ébullition, l’Allemand BioNTech a racheté ces derniers mois son rival CureVac, lui aussi pionnier de l’ARN messager pour environ 1,25 milliard de dollars. Mais la France, avec « des pionniers comme Éric Westhof à Strasbourg et des chimistes de l’ARN ce qui est très rare », n’est pas dépourvue d’atouts, fait-elle valoir.
À l’ART d’Orléans, « on produit différents ARN, on les encapsule pour pouvoir les livrer dans le corps humain », et « on les teste sur des cellules, pour vérifier qu’il n’y a pas de toxicité, et que ça fonctionne », résume M. Szymczak. On développe aussi une alternative à la production d’ARN in vitro, un procédé cher, souvent breveté par des entreprises américaines. Ils sont produits… dans des levures, divisant les coûts par 10 à 50 : reste à purifier les ARN ainsi obtenus pour répondre aux exigences de qualité du secteur pharmaceutique.
Une équipe travaille sur un traitement contre le cancer du pancréas, « cancer redoutable au taux de survie extrêmement faible, en raison d’un diagnostic souvent très tardif », explique le Dr Birane Beye, gastro-entérologue. « On est passé de 5 % en 2000 à 10 % aujourd’hui, soit 5 points de mieux en 20 ans, ce qui prouve que les thérapeutiques comme la chimothérapie ou l’immunothérapie ne marchent pas très bien », dit-il.
Face à l’urgence de développer des thérapies innovantes, l’Inserm mise sur une stratégie combinant un vaccin ARN et une technologie basée sur les ultrasons, explique le Dr Beye. « L’idée est, grâce à l’ARN messager, d’apprendre aux cellules immunitaires à se défendre contre ce cancer très agressif ».

Les ultrasons de haute fréquence, « très puissants », sont utilisés pour « entraîner à l’intérieur des tissus des vibrations qui vont générer des bulles de gaz : en explosant, ces bulles vont détruire la barrière entourant le cancer du pancréas, qui ressemble un peu à un bunker, et permettre au vaccin ARN de pénétrer dans la tumeur », poursuit le gastro-entérologue.
« On associe les deux pour booster le traitement », résume Mme Pichon. Des recherches complémentaires, menées au centre de recherches en cancérologie de Toulouse (CRCT), visent, elles, à « déjouer les astuces du cancer pour ne pas laisser la chimiothérapie fonctionner », précise-t-elle.
Pour l’heure, il a été prouvé que la technologie basée sur les ultrasons pouvait être utilisée sur le pancréas, et qu’elle améliorait les résultats de traitements classiques. Reste à le démontrer pour l’ARN messager. De nouveaux fonds seront nécessaires pour poursuivre ces recherches.


